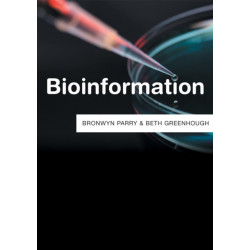
Bioinformation

Ingen varer
Der er 8+ underkategorier
Genetik (ikke-medicinsk)
Visning: Type : Alle | Sprog : Alle | Format : Alle
-
Bemærk: Kan ikke leveres før jul.
Equine Genomics (Bog, Hardback, Engelsk)The complete mapping of the horse genome sequence makes a significant contribution to understanding equine biology. This book provides a timely comprehensive overview of equine genomic research.
Levering: Skaffevare (forvent 14 - 30 hverdage) -
Bemærk: Kan ikke leveres før jul.
Cardiovascular Genetics and Genomics for the Cardiologist (Bog, Hardback, Engelsk)Promises to remodel the way cardiovascular medicine is practised * Written and edited by two pioneers in this area * Specially selected material for the practising clinician * Must-have reference to this developing field to ensure up-to-date patient care .
Levering: Skaffevare (forvent 14 - 30 hverdage) -
Bemærk: Kan ikke leveres før jul.
Breeding for Fruit Quality (Bog, Hardback, Engelsk)The global demand for high quality fruits that are rich in nutrients and that can endure the demands of worldwide supply chains is growing rapidly. Fruits are an important... Læs mere
Levering: Skaffevare (forvent 14 - 30 hverdage) -
Bemærk: Kan ikke leveres før jul.
Mammalian TRP Channels as Molecular Targets (Bog, Hardback, Engelsk)Transient Receptor Potential (TRP) genes were originally identified as encoding critical components of phototransduction in Drosophila. Since the discovery of... Læs mere
Levering: Skaffevare (forvent 14 - 30 hverdage) -
Bemærk: Kan ikke leveres før jul.
Encyclopedia of Molecular Biology, 4 Volume Set: 4 Volume Set (Bog, Hardback, Engelsk)The field of molecular biology has revolutionized the study of biology. The applications to medicine are enormous, ranging from diagnostic techniques for disease and genetic disorders, to drugs, to gene therapy.
Levering: Skaffevare (forvent 14 - 30 hverdage) -
Bemærk: Kan ikke leveres før jul.
Encyclopedia of Plant Pathology (Bog, Hardback, Engelsk)Plant pathology looks at the nature and control of plant diseases, it is a highly diversified science with many specialities and divisions. Topics covered in this book include nematology, physiology, virology, phytobacteria, epidemiology and mycopathology.
Levering: Skaffevare (forvent 14 - 30 hverdage) -
Bemærk: Kan ikke leveres før jul.
Encyclopedia of the Human Genome, 5 Volume Set (Bog, Hardback, Engelsk)Deals with the scientific basis of human genetics and genomics research and its ethical, philosophical, and commercial ramifications. This encyclopedia... Læs mere
Levering: Skaffevare (forvent 14 - 30 hverdage) -
Bemærk: Kan ikke leveres før jul.
Biomolecular Archaeology: An Introduction (Bog, Paperback / softback, Engelsk)Illustrated thoroughly, Biomolecular Archaeology is the first book to clearly guide students through the study of ancient DNA: how to analyze biomolecular evidence (DNA, proteins, lipids and carbohydrates) to address important archaeological questions.
Levering: 6 - 9 hverdage -
Bemærk: Kan ikke leveres før jul.
Bioinformation (Bog, Hardback, Engelsk)From DNA sequences stored on computer databases to archived forensic samples and biomedical records, bioinformation comes in many forms. Its unique provenance the fact that it is... Læs mere
Levering: Skaffevare (forvent 14 - 30 hverdage) -
Bemærk: Kan ikke leveres før jul.
Understanding Genetics: A Molecular Approach (Bog, Paperback / softback, Engelsk)This student textbook on modern genetics aims to focus on the essential aspects of molecular biology. It assumes an understanding of basic biology, genetics and simple statistics. Supported with numerous illustrations, the book explores all new advances in the field.
Levering: Skaffevare (forvent 14 - 30 hverdage) -
Bemærk: Kan ikke leveres før jul.
Toxicology and Epigenetics (Bog, Hardback, Engelsk)This book describes cutting-edge molecular technologies to unravel epigenetic changes, the use of in vivo and in vitro models, as well as the potential use of toxicological epigenetics in regulatory environments.
Levering: Skaffevare (forvent 14 - 30 hverdage) -
Bemærk: Kan ikke leveres før jul.
The AGT Cytogenetics Laboratory Manual (Bog, Hardback, Engelsk)Cytogenetics is the study of chromosome morphology, structure, pathology, function, and behavior. The field has evolved to embrace molecular cytogenetic changes, now termed cytogenomics.
Levering: Skaffevare (forvent 14 - 30 hverdage)